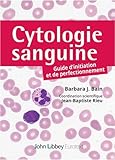
Cytologie sanguine

Renseignements
Actualités et nouveautés
Boîte à outils pour la réussite
- Je gère ma réussite
- Philo-aide (Pour accompagner la rédaction du texte argumentatif philosophique)
- Ouvrir le dico (Mieux connaitre le dictionnaire pour s’améliorer en français)
Étapes pour une recherche documentaire réussie
Accueil
Accès rapide aux outils de recherche
| Connexion aux ressources numériques |
Livres numériques
Revues et journaux
Encyclopédies, dictionnaires et atlas
Images, films et vidéos éducatives
Outils spécialisés en sciences, technologies et santé
Outils de données statistiques
Publié le 2022-06-03
Droit d'auteur - Pour les enseignants
- Copibec - Licence collégiale - Déclaration du droit d'auteur (Personnel enseignant)
- Procédure de création de compte et déclaration Copibec
- L'essentiel du droit d’auteur
- Copibec - Licence collégiale
Droit d'auteur
Pour le personnel autre qu'enseignant
- Copibec - Licence collégiale - Déclaration du droit d'auteur - LIVRES (Personnel professionnel et de soutien)
- Copibec - Licence collégiale - Déclaration du droit d'auteur - ARTICLES DE JOURNAUX et PÉRIODIQUES (Personnel professionnel et de soutien)
- L'essentiel du droit d’auteur
- Copibec - Licence collégiale
Intégrité intellectuelle
- Carte interactive - Intégrité intellectuelle
- Utilisation intègre des outils de l'IA générative
- Mon travail est-il prêt à être remis ?
- Documents de référence en matière de plagiat (enseignants)
- Documents de référence en matière de plagiat (étudiants)